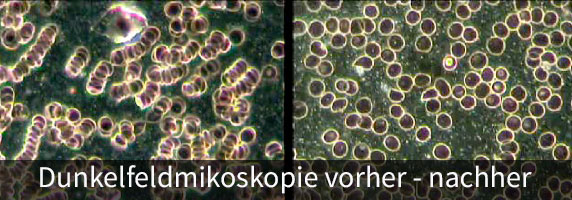
Dunkelfeldmikroskopie - wie wirkt die Magnetfeldtherapie

Magnetfeldtherapie bei Therapeuten
Viele Therapeuten vertrauen Naturheilverfahren. Therapeuten der Alternativmedizin setzen auf die Heilkräfte der Natur, Schulmediziner nutzen alternative Therapien wie die Akupunktur oder auch die Magnetfeldtherapie.
Ärzte und diverse Kliniken nutzen die Magnetfeldtherapie.
Dazu zählen Mediziner aus unterschiedlichsten Gebieten:
- Chirurgie
- Dermatologie
- Gynäkologie
- Hämatologie
- HNO
- Innere Medizin (Internisten)
- Immunologie
- Neurologie
- Orthopädie
- Psychiatrie
- Sportmedizin
- Urologie
Heilpraktiker fördern bewußt die Selbstheilungskräfte des Körpers.
Dazu setzen sie verschiedenste, natürliche Therapien ein. Gewünschte Ziele sind:
- Verbesserung der Sauerstoffversorgung
- Verbesserter Abbau von Schlackenstoffen
- Stärkung des Immunsystems
- Entgiftung des Körpers
- Schnellere Regeneration
Heilpraktiker behandeln mit natürlichen Therapien bei folgenden Indikationen:
Allergien; Arthritis; Arthrose; Bronchitis; Depressionen; Durchblutungsstörungen; Entzündungen; Gelenkproblemen; Golfarm; Hämatome; Herzbeschwerden; Ischias; Kreislaufstörungen; Migräne; Muskelverspannungen; Osteoporose; Prellungen; Rückenbeschwerden; rheumatische Erkrankungen; Schlafstörungen; Sportverletzungen; Tennisarm; Tinnitus; vegetative Dystonie; Zerrungen.
Heilpraktiker, welche bereits die Magnetfeldtherapie nutzen finden Sie auf der Homepage: magnetfeld-therapeuten.de
In der Physiotherapie kann die Magnetfeldtherapie vielfältig eingesetzt werden. Auch viele Hochleistungssportler setzen auf die Magnetfeldtherapie in Wettkampf- und Regenerationsphasen.
Oft nutzen Physiotherapeuten die Magnetfeldtherapie ergänzend zu anderen Behandlungen wie beispielsweise Massagen.
Physiotherapeuten, welche bereits die Magnetfeldtherapie nutzen finden Sie auf der Homepage magnetfeld-therapeuten.de.
Unser Service für Ärzte und professionelle Anwender
Als Partner für professionelle Anwender der Magnetfeldtherapie bieten wir für Mediziner und Heilpraktiker viele Serviceleistungen:
- Erweitern Sie Ihr Praxisangebot!
- Wir beraten Sie bei der Planung und der Etablierung der Magnetfeldtherapie in Ihrer Praxis
- Sie erhalten eine professionelle Schulung zu Ihren Systemen und zu den Anwendungsmöglichkeiten
- Nutzen Sie unsere Fortbildungsmaßnahmen. Wir informieren Sie hierzu gerne persönlich
- Als unser Partner haben Sie Zugang zur ärztlichen Hotline für Magnetfeldtherapie

Gesund ohne Chemie
Viele Menschen entscheiden sich inzwischen dafür, auf Chemie weitestgehend zu verzichten.
Ein Beispiel ist die traditionelle Chinesische Medizin (TCM). Seit mehr als tausenden Jahren heilt die TCM mit Hilfe natürlicher Therapien (Beispiel Akupunktur). Die Magnetfeldtherapie ist auch eine alte Therapieform welche mit moderner Technik perfektioniert wurde.
Die Veränderungen sind messbar!
Mittels Dunkelfeldmikroskop kann man beobachten, wie sich durch die Einwirkung eines pulsierenden Magnetfeldsystems die roten Blutkörperchen in Ihrer Fließeigenschaft verändern. Die sogenannte Geldrollenbildung verändert sich schon nach wenigen Minuten Anwendung auf einem Magnetfeldsystem . In unserem Studio führen wir Energiestatusmessungen durch und zeigen Ihnen, welche Veränderungen durch eine Anwendung möglich sind.
Therapeuten für Magnetfeldtherapie
Wenn Sie als Therapeut in Ihrer Praxis ein Magnetfeldsystem einsetzen möchten, nehmen Sie Kontakt mit uns auf. Wir beraten Sie gerne.
Falls Sie schon die Magnetfeldtherapie anbieten, nehmen wir Sie gerne in unser Verzeichnis für Therapeuten auf.
